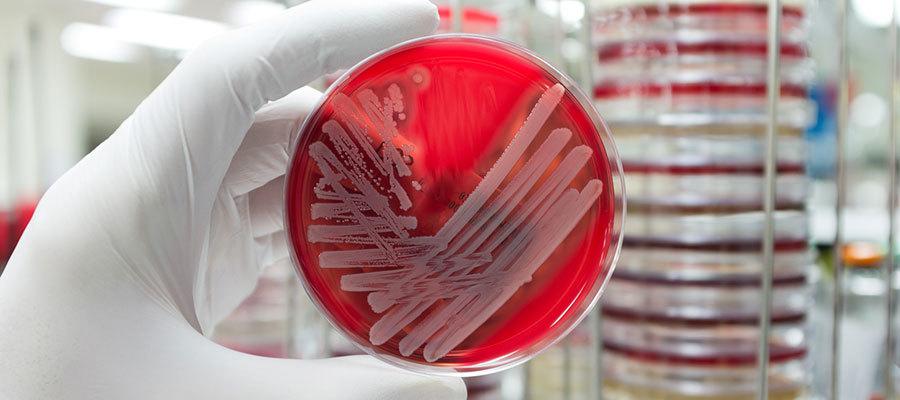
anitbiotic resistance

CDC Urges Aggressive Action to Stop Spread of Antibiotic-resistant Germs
The Centers for Disease Control and Prevention today urged state and local health departments and health care facilities to work with its Antibiotic Resistance Lab Network to implement a coordinated strategy to prevent the spread of unusual germs that are resistant to all or most antibiotics or can spread their resistance to other germs, reporting more than 220 instances of such germs in the United States last year. The strategy calls for rapid identification of resistance, infection control assessments, testing patients who are without symptoms but possibly carrying and spreading the germ, and continued infection control assessments until spread is stopped. “CDC’s study found several dangerous pathogens, hiding in plain sight, that can cause infections that are difficult or impossible to treat,” said CDC Principal Deputy Director Anne Schuchat, M.D. “It’s reassuring to see that state and local experts, using our containment strategy, identified and stopped these resistant bacteria before they had the opportunity to spread.” For more on the CDC study and strategy, visit https://www.cdc.gov/vitalsigns/containing-unusual-resistance. CDC also will host an April 10 Town Hall Teleconference (https://www.cdc.gov/stltpublichealth/townhall/2018/4-apr.html) on how states are implementing the strategy. For additional tools to prevent antibiotic resistance, including an antimicrobial stewardship toolkit, visit http://www.ahaphysicianforum.org/resources/appropriate-use/antimicrobial.

